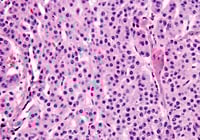

ルタテラ NEN(神経内分泌腫瘍)の鑑別診断
画像ご提供:関西電力病院 外科 部長 河本 泉 先生
|
機能性NENの診断
インスリノーマ
インスリノーマの診断は意外と難しいのが特徴です。絶対的な鑑別診断法がないのです。鑑別すべき疾患は、表1に挙げています。
検査法としては、絶食試験やCペプチド抑制試験それにセクレチン静注試験が有用です。絶食試験では、24~72時間水分のみを投与して低血糖が起きるかどうか調べます。絶食して24時間以内に80%、48時間以内で90%、72時間では100%のインスリノーマの患者さんで低血糖とそれによる症状が出現して診断がつくとされています。しかし、現実には難しい場合もあります。
Cペプチド抑制試験は、異種インスリンを30分間点滴静注しながら、Cペプチドの濃度を測定して、血糖低下とインスリン濃度上昇に反応しない自律的インスリン分泌があるかどうかを判定する検査です。
セクレチン試験は、セクレチン2U/kg体重を20秒ほどで静注後に、血中インスリン値が前値に比し2倍以上かつ10μU/mL以上の上昇を示すか否かで判定する検査です。正常なB細胞はセクレチンの刺激で陽性反応を示しますが、インスリノーマ患者さんの場合正常B細胞のインスリン分泌機能が低下していますので陰性反応を示します。ただし、ソマトスタチンアナログ投与中にはB細胞の機能が回復しているので陽性に近い反応を示します。
以上のような鑑別診断法とは別に、CTやEUS、体外USなどの画像診断法で腫瘍が見つかれば、それが局在診断になることも多くあります。腫瘍が小さくて見つからない場合には、グルコン酸カルシウムを用いるSASI Testを行うのも有用です。
ガストリノーマ
鑑別すべき疾患は表1に挙げています。検査としては、胃酸の過剰分泌と血清ガストリン濃度の上昇が同時的に存在することを証明するために、胃酸分泌検査か24時間pHモニター、そして血清ガストリン濃度測定が行われます。血清ガストリン濃度は、胃切除後の患者さんでは60pg/mL以上を異常値と設定します。
セクレチン静注試験も有用ですが、萎縮性胃炎などでの高ガストリン血症の患者さんでも血清ガストリン濃度30%程度の上昇がみられるので注意が必要です。ガストリノーマの患者さんでは100%以上の上昇がみられます。
グルカゴノーマ
特徴的な移動性融解性紅斑が大腿部から会陰部にあって、高グルカゴン血症があれば確定します。糖尿病状態、血中低アミノ酸血症や体重減少を来していることも診断の参考になります。
VIPオーマ
老人での発症もあり鑑別診断が困難ですが、激した下痢の患者さんに出会った時にこの腫瘍を思い出せれば、血中VIP濃度測定で確定します。水様性下痢のために低カリウム血症を来す状態まで電解質異常が進展します。膵のみならず十二指腸にも発生します。
ソマトスタチノーマ
膵と十二指腸に発生します。無症状の場合も多いですが、脂肪性下痢や糖尿病を発症します。膵ソマトスタチノーマは通常1cm以上で見つかっていますが、十二指腸ソマトスタチノーマは比較的小さいのが特徴です。多くの患者さんで糖尿病、胆石症や低塩酸症などを合併しています。
診断は、血中ソマトスタチン濃度測定をすれば診断できますが、ほとんどの患者さんで切除後の標本を免疫組織学的に染色することにより診断されているのが現状です。肝転移を50%以上と高率に来し、予後も良くないので早期切除が推奨されます。
カルチノイド腫瘍
カルチノイドは90%が消化管全域から発生しますが、膵、呼吸器や胸腺からも発生します。肝転移を来していない場合には、非機能性腫瘍として偶発的に見つかることが多いのですが、肝転移を来すと転移巣から分泌されるセロトニン、タキキニンなど種々の活性ペプチドにより、皮膚のFlushing(潮紅)、下痢、心臓の内膜に蓄積するコラーゲンによる弁膜症に伴う弁狭窄や逆流などの重篤な心機能障害、気管支痙攣など、重篤な症状を発現して、生命の危険を招きます。欧米では、十二指腸、小腸、盲腸、右半結腸などのmidgutいわゆる中腸の発生が多く、小腸閉塞患者の30~40%を占めるとされていますが、本邦ではより予後の良い胃と直腸の小さなカルチノイドが多く、midgutでの発生は少なくなっています。
鑑別診断は各臓器により異なってきますが、非機能性腫瘍として見つかった場合に行われる無侵襲の検査としては、24時間尿中の5-ハイドロキシインドール酢酸(5-HIAA)測定と血中クロモグラニンA※の測定が国際的に用いられています。しかし、本邦では後者の測定は認可されていません。なお、最終的診断は、生検による組織学的診断をすることで得られます。
※本邦未承認

クロモグラニンA※
HE

シナプトフィジン
表1 機能性膵・消化管NENの症状と鑑別が必要な疾患・病態
主な症状・徴候 | 鑑別が必要な疾患・病態 | |
インスリノーマ1,2) | 低血糖症状
| インスリン自己免疫症候群、アルコール性肝障害、外因性インスリン飢餓(摂食障害)、胃術後、NIPHS |
ガストリノーマ (Zollinger-Ellison症候群)1,2) |
| 通常の消化性潰瘍、プロトンポンプインヒビター内服、萎縮性胃炎、慢性腎不全、G細胞過形成 |
グルカゴノーマ1,2) |
| 他の皮疹、糖尿病、栄養障害、慢性腎不全 |
VIPオーマ (WDHA症候群)1,2) |
| 感染性下痢症、緩下剤の過量使用、カルチノイド症候群 |
カルチノイド症候群1,3) |
| 膵外分泌機能不全、過敏性腸症候群 |
NIPHS: non-insulinoma pancreatogenous hypoglycemia syndrome, WDHA: watery diarrhea hypokalemia achlorhydria
1)Ito T, Jensen R. Expert Opin Pharmacother. 2021; 22: 685-693.
2)河本泉、今村正之. 日消誌. 2014; 111: 2263-2271.
3)Khan MS, et al. World J Gastroenterol. 2020; 26: 4537-4556.より作成
参考文献
今村正之 監. 膵・消化管神経内分泌腫瘍(NET)診断・治療実践マニュアル, 総合医学社, 東京, 2011
非機能性NENの鑑別診断
非機能性NENは症状が出現しないため、画像検査で偶発的に発見されることが多い疾患です。
膵NENの鑑別
膵NENは通常型膵癌との鑑別が重要となります。
通常型膵癌は、造影CTでは境界不明瞭な乏血性の不整形腫瘤として描出されます。これに対し、典型的な膵NENは、造影CTで早期濃染を認める境界明瞭な多血性腫瘤として描出されることから両者の鑑別は比較的容易です。しかし、腫瘍径が大きく、増殖能の高い膵NENでは早期造影効果を示さないこともあり、注意が必要です。また、膵NENは通常、主膵管から離れた膵実質に発生するため、主膵管に影響を及ぼすことは少ないのですが、稀に主膵管の狭窄や途絶を認めることもあります。このような非典型例に対しては、造影CTに加えて、造影MRI、ソマトスタチン受容体シンチグラフィ(SRS)、PET-CTなどの各種画像モダリティを組み合わせて総合的に診断していく必要があります。
消化管NENの鑑別
消化管NENは粘膜深層に存在する内分泌細胞(ECL細胞)由来の病変であり、上皮性腫瘍ですが粘膜下腫瘍様形態を呈します。
胃NENや直腸NENの典型例は、黄色調で表面の血管拡張を伴う粘膜下腫瘍様隆起であり、サイズが大きくなると陥凹やびらんなどを伴うこともあります。深達度診断のため、超音波内視鏡検査(EUS)を実施すると、第2~3層を主座とする境界明瞭な低エコー腫瘤像が見られます。小腸NENは頻度が稀であり、腫瘍が大きくなるまで症状が出ないため早期診断は困難です。他疾患の画像診断で、腹部腫瘤などで見つかることがあります。
参考文献
三浦孝之、他. 日本臨牀 2020; 78 増刊号4: 737-742
藤森 尚、他. Pharma Medica 2021; 39: 66-72